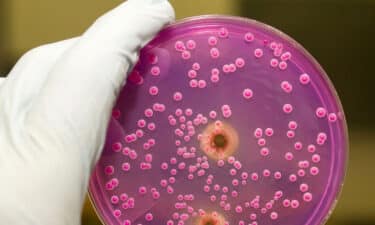

maya
- Nis- 2020 -17 NisanBeslenme

Ekşi Mayalı Ekmek Nasıl Yapılır? Tüm Detaylarıyla Ekşi Maya Ekmek Tarifi
Ekşi mayalı ekmek nasıl yapılır? Sorusuna cevap veren Türkçe ve yabancı yüzlerce web sayfası veya youtube kanalına rast gelmişsinizdir. Bu…
Devamını Oku » - Eki- 2019 -14 EkimBeslenme

Kombu Çayı Nasıl Yapılır? 7 Muhteşem Faydası ve Yan Etkileri
Kombu çayı, fermente edilmiş bir içecek olarak son yıllarda popülerlik kazanmıştır. Hem lezzeti hem de sağlık açısından sunduğu çeşitli faydaları…
Devamını Oku » - Nis- 2019 -5 NisanHastalıklar

Candida Albicans Mantarı Nedir? Belirtileri ve Tedavisi Nelerdir? Nasıl Beslenmeli?
Candida mantarı, insan vücudunda doğal olarak bulunan bir mantar türüdür. Genellikle ağız, bağırsaklar, deri ve vajina gibi bölgelerde yaşayan bu…
Devamını Oku » - May- 2017 -29 MayısBeslenme

Ekşi Mayalı Ekmek: Sağlığa Faydaları ve Hastalıklar
Ekşi Mayalı Ekmek yerine çabuk yapılan ekmek günümüz diyetindeki en yıkıcı uygulamalardan biridir ve normal beslenme haline gelmiştir. Doğru işlenmemiş…
Devamını Oku »